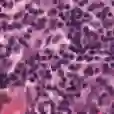
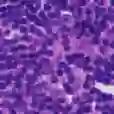

Responding appropriately to the detections of a sequential change detector requires knowledge of the rate at which false positives occur in the absence of change. Setting detection thresholds to achieve a desired false positive rate is challenging. Existing works resort to setting time-invariant thresholds that focus on the expected runtime of the detector in the absence of change, either bounding it loosely from below or targeting it directly but with asymptotic arguments that we show cause significant miscalibration in practice. We present a simulation-based approach to setting time-varying thresholds that allows a desired expected runtime to be accurately targeted whilst additionally keeping the false positive rate constant across time steps. Whilst the approach to threshold setting is metric agnostic, we show how the cost of using the popular quadratic time MMD estimator can be reduced from $O(N^2B)$ to $O(N^2+NB)$ during configuration and from $O(N^2)$ to $O(N)$ during operation, where $N$ and $B$ are the numbers of reference and bootstrap samples respectively.
翻译:对测出连续变化探测器的适当反应要求了解在无变化的情况下出现假阳性的速率。设定探测阈值以达到理想的假正率是具有挑战性的。现有的工作采用设定时间变化阈值的办法,在无变化的情况下侧重于探测器的预期运行时间,要么将其与下方松绑,要么直接针对它,但以我们所显示在实践中造成重大误差的无药可救的论据为依据。我们采用模拟方法设定时间变化阈值,使预期的运行时间能够准确锁定目标,同时进一步保持跨时间步骤的假正率不变。尽管设定阈值的方法是计量的,但我们表明使用流行的四边时间MMMMS估计值的成本如何在配置期间从$O(N%2B)降低到$O(N%2+NB),在操作期间从$O(N2)降低到$O(N),在操作期间,其中,以美元和$B$分别是参考和靴带样品的数量。